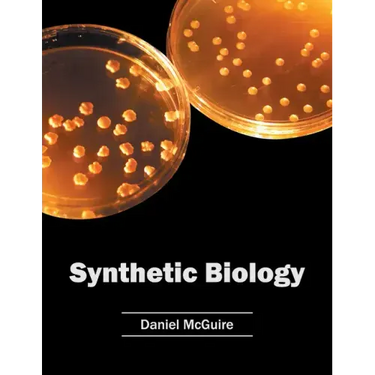
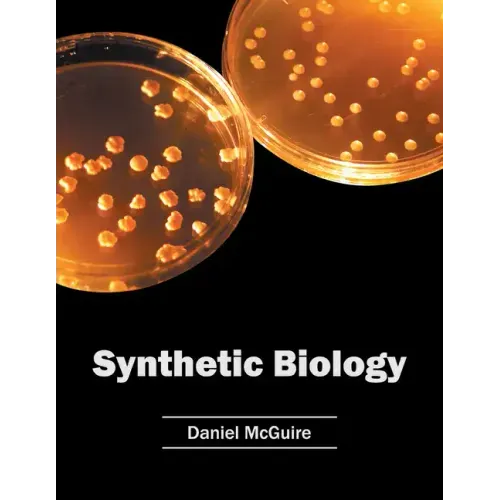

Synthetic Biology - Hardcover
 Synthetic Biology - Hardcover
$163.99
/
Synthetic Biology - Hardcover
$163.99
/

Your payment information is processed securely. We do not store credit card details nor have access to your credit card information.
by Daniel McGuire (Editor)
Synthetic biology is a rapidly evolving discipline which integrates concepts of engineering with that of biology. It is a field which has applications in a number of innovative fields, such as diagnostics, designing innovative biological systems to fabricate materials, etc. This book includes some of the vital researches being conducted across the world, on various topics related to synthetic biology, such as cell design, synthetic DNA, designed proteins, biosensors, etc. As this field is emerging at a rapid pace, the contents of the text will help the readers understand the modern concepts and applications of the subject. It is highly recommended for students and academicians pursuing synthetic biology, biotechnology and allied fields of study.